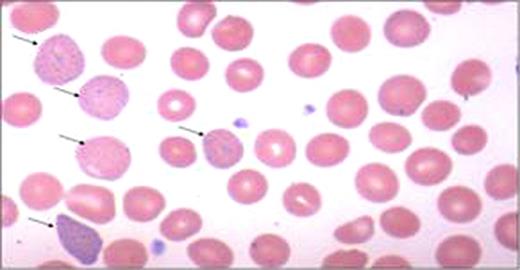
graphic

Abstract
Abstract 4814
Diagnosis of unstable hemoglobins can be challenging, especially those involving the α globin chain. We present here an extremely rare unstable hemoglobin variant in a black female. A 30 y/o female from Haiti presented in the third trimester of pregnancy with anemia. She reported a low Hb in 2007 prior to a myomectomy and dark urine post exercise and in the morning but was otherwise entirely asymptomatic. Her mother and sister had sickle cell trait, but she tested negative; no other familial blood disorder history was elicited. Physical exam was remarkable only for mild pallor; splenomegaly was not appreciated with advanced pregnancy. Laboratory data revealed a Coombs negative hemolytic anemia with Hb values between 9–11g/dl, MCV of 97, reticulocyte count of 7.3%, LDH between 600–800, bilirubin of 1.2 –mostly indirect and a mild elevation of AST at 46. Haptoglobin was undetectable. Peripheral blood smear review showed
moderate basophilic stippling and polychromasia (Figure 1). Heinz body preparation and testing for PNH were negative. RBC enzyme panel was normal including 5′ nucleotidase levels. IEF was performed on a thin-layer agarose gel (RESOLVE Hemoglobin kit) with a pH range of 6.0–8.0, according to the manufacturer's instructions (Perkin Elmer Life and Analytical Sciences, Norton, OH, USA). Quantitative analyses of hemoglobin was done by Cation Exchange HPLC by using a Synchropak CM-300, 250mm × 4.6mm, 6u column (Eprogen Inc., Downers Grove, IL, USA) and the globin chains were separated on Reverse Phase HPLC with a Discovery BIO Wide Pore C5, 250mm × 4.6mm, 5um column (Supleco, Bellefonte, PA, USA). Isopropanal stability test was negative. DNA was isolated from peripheral blood leukocytes using QIAamp DNA Blood Mini Kit, according to manufacturer's instructions (QIAGEN Inc, Valencia, CA, USA). Segments of the genomic DNA were amplified by polymerase chain reaction (PCR) using target specific primers flanking Exons I, II, and III of the a1 and a2 genes. IEF revealed Hb A, A 2, and a variant “S” like band (<1%) (Figure 2). However, Cation exchange HPLC revealed 97.0% Hb A, 2.5% Hb A2 and 0.5% Hb F without detection of variant band. Reverse phase HPLC showed only βA and αA
chains without any detectable abnormal chains. Sequencing of the PCR amplified a2 gene revealed heterozygosity for TCTàCCT mutation (Ser131Pro) at codon 131 (Hb Questembert), Exon III (Figure 3). The a1 gene was normal. Hb Questembert is an extremely rare unstable Hb having been reported in French and French-Yugoslavian families. Although it is highly unstable, since the amount of variant hemoglobin is <1.0% and therefore not detectable on cation exchange HPLC, reverse phase HPLC, or unstable hemoglobin test. Our patient was entirely asymptomatic with periods of increased hemolysis during stress; she had never been transfused including during prior pregnancies. The mechanism by which this variant is unstable is highly complex. The substitution of Proline for Serine at a2 131 approximately mid way along the H helix next to heme contact residue 132 (H15) Val, disrupts the a helical structure leading to an unstable a-globin chain. The lack of family history (de novo mutation), a negative stability test, absence of a readily detectable variant hemoglobin do not readily suggest the presence of an unstable hemoglobin in this case. This patient highlights the importance of a molecular diagnostic approach in reaching the correct diagnosis in patients with a chronic, Coombs negative hemolytic anemia.
Alpha-2/Exon III/Codon 131 T à C/Ser131Pro/Hb Questembert/Heterozygous
No relevant conflicts of interest to declare.
Author notes
Asterisk with author names denotes non-ASH members.